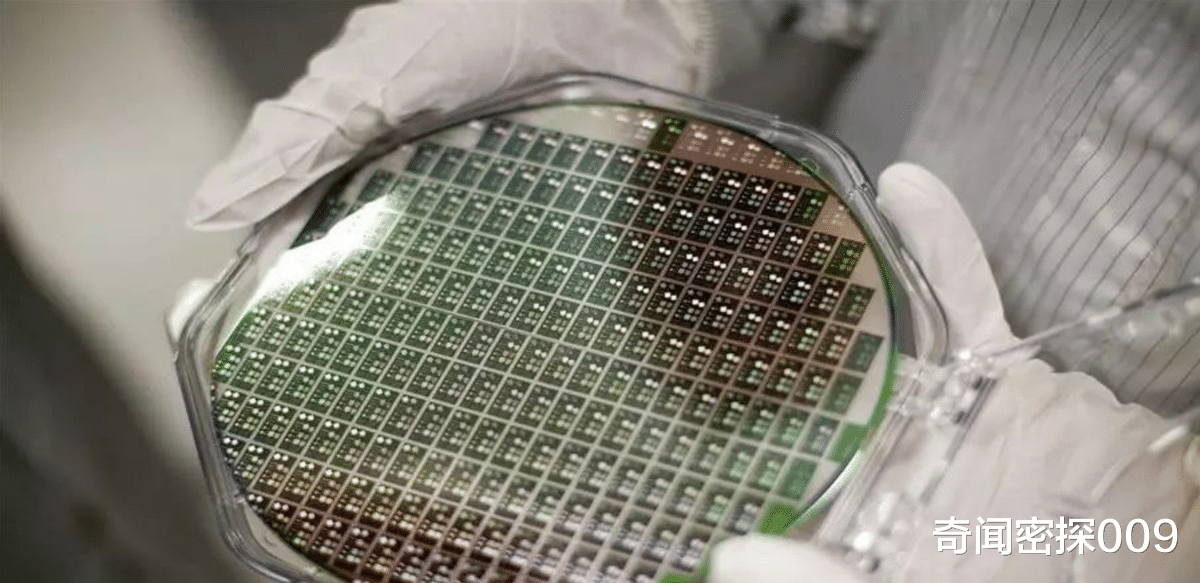
芯片|平民版“孟晚舟”：国内芯片领军人物，是如何被美国诱捕的？

文章图片

文章图片

文章图片

文章图片

文章图片

文章图片

最近 , 半导体界又有大事发生 , 国内的知名的半导体企业诺思微终于完成了4个亿的融资 。 让这家公司备受瞩目的是 , 这家公司主攻的正是前段时间华为被卡脖子的射频芯片 , 当然除此之外 , 这家公司还与一位科学家被美国栽赃陷害的冤情有关 。
最近 , 芯片界又迎来了好消息 , 知名的半导体企业诺思微 , 成功完成近4亿人民币股权融资 。 这次融资的目标是助力诺思微进一步加大在新产品研发的投入 , 预计在一年内全面加速产能释放 , 达年产20亿颗滤波芯片的产能规模 , 助力国内射频芯片产业发展 。
提到诺思微威 , 大家可能大家可能都会想到该公司的联合创始人——张浩 。 2015年5月 , 当时的美国总统还是奥巴马 , 以涉嫌经济间谍罪及盗窃商业机密罪逮捕了张浩及其他的五名中国公民 。
张浩是国内射频芯片领域的领军人物 。 美国诱捕张浩教授 , 很明显就是处心积虑给张浩安上莫须有的罪名 , 以此达到限制中国射频芯片发展的目的 。 不仅如此 , 美国自己还窃取了张浩的专利技术制造芯片 , 那么美国是如何诱捕张浩教授的呢?
张浩被诱捕过程张浩是天津人 , 曾在美国南加州大学获得电气工程博士学位 , 毕业后直接就职全球无线射频器件的龙头企业思佳讯 , 当时在美国时 , 他就已经是滤波芯片的领军人物 , 并且在美国专利部的批准下 , 获得了7项专利 。
滤波芯片 , 被视为芯片界中“皇冠上的明珠” , 同时也是现代无线通信、5G、物联网、人工智能行业的核心与基石 , 因此 , 在互联网时代 , 滤波芯片更是必不可少的存在 。
在他就职于思佳讯的时候 , 认识了在安华高工作的庞慰 , 安华高同样是国际上知名的半导体企业 , 因此两人可以说是棋逢对手 , 志趣相投 , 很快便成为了好友 。 他们在国外眼看中国的科技发展迅猛 , 便决定一起回国发展 , 于是在09年的时候 , 两人一同辞去在美国的工作 , 并且一起回到天津大学任教 。
但没想到回国却发现 , 国内90%的滤波芯片的份额都被美国独占 , 剩下的10%左右的市场份额则被韩日等国瓜分 , 会出现这种情况是因为中国根本没有自己的射频公司 , 中国一直到90年代才有自己射频公司 , 而且生产出来的芯片也差强人意 , 根本比不上国外的射频技术 , 这就导致了我国的手机产量虽然年年攀升 , 但每部手机用的却都是外国的技术 , 也因此我们必须向美国缴纳巨额的专利费用 。
为了改变这种局面 , 两人决定合办一家公司 。 2011年 , 在天津大学的支持下 , 他们同学校的另几位老师一起创办了诺思微系统有限公司 , 简称诺思微 , 这家公司专门从事被美日两国垄断的射频滤波器的研究开发工作 , 张浩在其中担任诺思微的首席科学家 。
这家诺思微是国内首家射频滤波芯片生产公司 , 创建之初就发展迅速 , 不仅在领域内有突破性的研究 , 也成了国内少数专注于这个领域的企业 , 此外 , 诺思微微还是垂直整合制造模式的企业 。 所谓垂直整合制造模式就是指一个产品从原料到成品 , 到最后到消费者手中的多个阶段都在一家公司进行 , 因此这家公司的自主化程度很高 , 而且在成立后不久 , 诺思微就有了多项核心产品技术 , 达到了国际领先水平 , 在当时很多人都看好诺思微的发展 , 并将它视为国内打破滤波器被国外垄断的先锋 。
在张浩为自己的新公司忙得不可开交的时候 , 没想到自己之前的老东家——美国思佳讯不行了 , 甚至还将当时张浩负责的滤波器业务卖给当时的安华高 , 一时间 , 安华高成为了垄断世界滤波器的存在 。
- 芯片|功率半导体有多紧俏?博世亲自下场生产碳化硅芯片,目标产能上亿颗!
- playstation5|手慢就没有了!索尼PS5国行版将在双十二补货:库存一万台
- 英特尔|英特尔正在通过非K版本的Alder Lake改变现状
- 优派|美国很满意:150多家芯片厂商,都“自愿”提交了详细数据
- iqoo|IP68+144Hz!独显芯片+5500mAh,iQOO9 Pro不再低调
- 芯片|谁能救滴滴?
- 华为mate20pro|一台3年前256G版本的华为Mate20Pro放现在,相当于啥价位的手机?
- iPhone|800亿没白出,台积电3nm芯片被确认,iPhone14配置良心有加
- Pixel|旗舰芯片市场格局变了,4nm旗舰之争联发科优势形成
- 原创|别花冤枉钱,我教你怎么样给电脑装系统,安装版与Ghost都不难!
